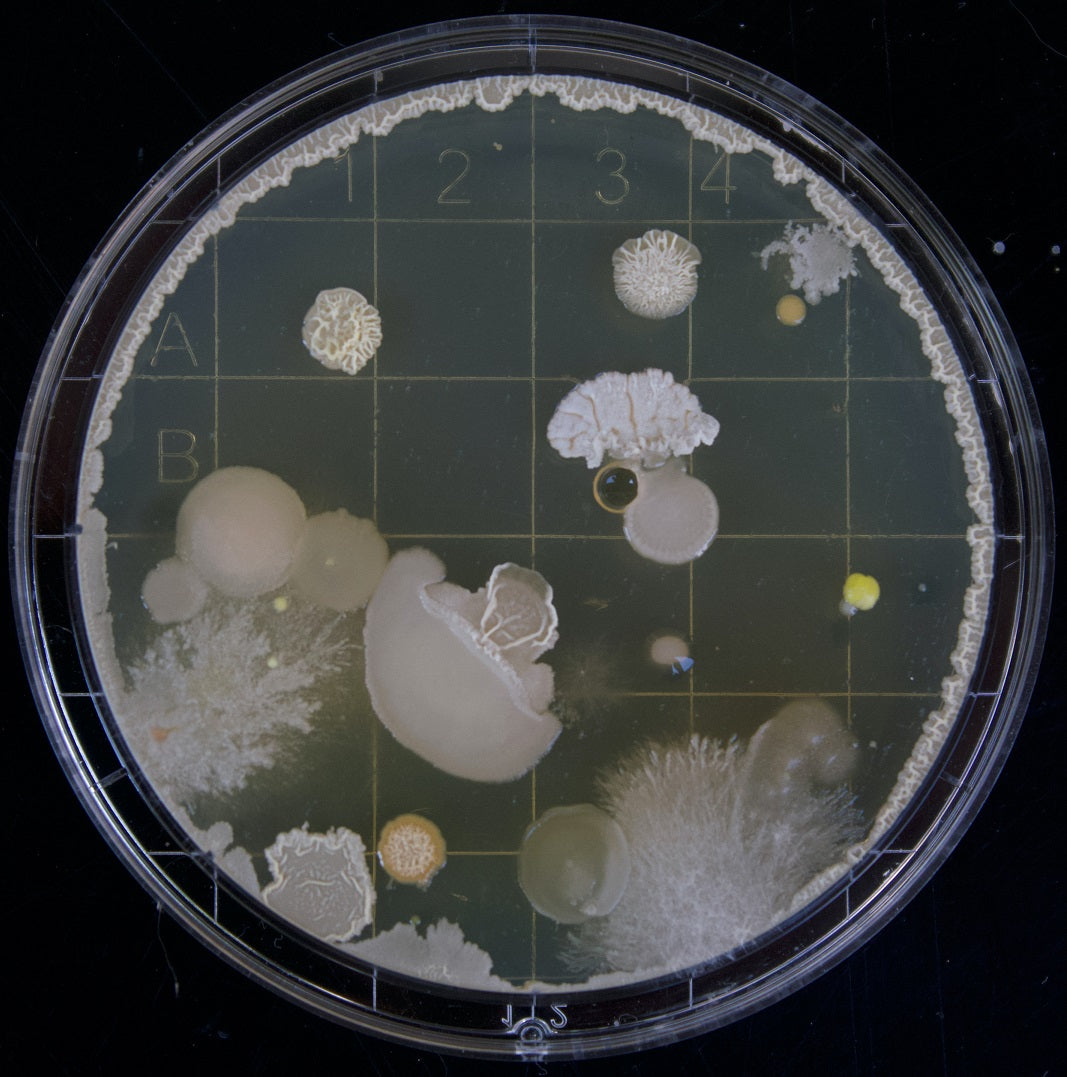

WANT TO LEARN MORE ABOUT UMAMI?
Subscribe to our monthly Newsletter to learn more

What is umami?
In a nutshell, Umami translated from Japanese as “essence of deliciousness” was described and named by the Japanese chemist Kikunae Ikeda in 1908 and is thought as the savoury / meaty taste that results from the stimulation of the receptors in our taste buds by molecules such as amino acids (glutamic acid in the form of glutamate) and nucleotides (5’-inosinate and 5’-guanylate) (Kurihara, 2015).

What are amino acids?
Amino acids consist chemically of a carboxylic acid (-COOH) and an amino (-NH2) functional group and can be linked together by a peptide bond to form polypeptides. A polypeptide made of 50 or more amino acids is referred to as protein. These macromolecules (large molecules) are involved in every biological process including cell growth, metabolism, digestion, respiration, and reproduction. Thus, amino acids are the fundamental building blocks of living organisms. Even though there are hundreds of amino acids in nature, only 22 amino acids are required to create all the proteins found in the human body and most other forms of life (Becker & Kleinsmith, 2009).

What is MSG?
Monosodium glutamate (MSG) is the sodium salt of glutamic acid and can be found in a variety of foods, including tomatoes, mushrooms, seaweed, fish, cheese and other fermented food. While attempting to unleash the secret behind the tastiness of many Japanese broths / soups that are made of kombu, an edible seaweed, Prof. Kikunae Ikeda, was able to identify and isolate the major compound that is responsible for the tasty broth as MSG (Mouritsen & Styrbæk, 2014).

What are nucleotides?
Nucleotides consist of a nucleobase, a sugar (ribose or deoxyribose) and a phosphate group. Several nucleotides link together make long chains of nucleotides called polynucleotides which can then form nucleic acids like DNA (deoxyribonucleic acid) or RNA (ribonucleic acid), the essential building blocks for all living organisms on earth. In DNA, there are four nucleobases: guanine, adenine, cytosine, and thymine. In RNA, thymine is replaced by uracil (Becker & Kleinsmith, 2009).
What happens during fermentation?
Long before the science of fermentation was discovered, people utilised fermentation to generate food and drinks with intensified flavours. The scientific discoveries of French scientist Louis Pasteur, who demonstrated that fermentation is initiated by microorganisms (yeasts, moulds, and bacteria), enabled us to comprehend the fermentation process in more depth and appreciate its essential health benefits (Mouritsen & Styrbæk, 2014).

What's in miso?
Miso is a traditional Japanese condiment, a thick paste produced from fermented soybeans containing salt, koji (fungus species Aspergillus oryzae) and different types of cereal grains. During the fermentation process, enzymes from the fungus, lactic acid bacteria, and yeast break down the organic compounds in soybeans and the cereal grains resulting in a thick soybean paste.
WHY IS UMAZING GOOD FOR YOU?
The health benefits of umami is strongly dependent on the ingredients we choose.

Collapsible content
Health benefits of Umami
Various studies have shown that a high-salt intake is linked to hypertension, which is a key risk factor in cardiovascular and kidney diseases. Therefore, dietary guidelines recommend the reduction of salt intake, outlining that the major salt source comes from processed foods, condiments, and canned foods (Durack et al., 2008; He et al., 2014). According to research, using umami flavour in a low-salt diet promotes food palatability and can give bland food in depth flavour (Yamaguchi & Ninomiya, 2000).
In addition, our sense of taste and smell can be compromise due to the ageing process, environmental factors or due to other causes, using umami's flavour-enhancing characteristics to create intense flavours can therefore be good for meals served in hospitals and nursing homes for the elderly (Ninomiya, 2015; Pacheco Arnaiz & Khakim, n.d.; Yamamoto et al., 2009).
More recent research has shown that consuming umami-rich meals can help ease the severe condition of dry mouth in the elderly, since umami initiates salivation (Hodson & Linden, 2006; Satoh-Kuriwada et al., 2009).
Each taste is thought to fulfil an evolutionary purpose to either keep us away from poisonous or spoiled food or drawn us to energy-dense and nutritious food. Humans experience umami for the first time through the free amino acids in mother’s milk (breast milk) where glutamic acid exhibits the highest concentration in total amino acid as well as free amino acid contents. The free (unbound) glutamic acid in form of its salt glutamate is the main compound unleashing the umami taste (Ballard & Morrow, 2013; Csapó & Salamon, 2009). Thus, research so far has led to the conclusion that umami taste is important evolutionary to detect nutritious and protein-rich food which contains essential building blocks for our development and growth.
While glutamic acid is abundant in both plant and animal, the nucleotides 5’-inosinate is more abundant in meats and 5’-guanylate can be mainly found in plants and mushrooms, such as Shiitake mushrooms (Kurihara, 2015). Studies have shown that these molecules together with glutamate enables the so-called umami synergy, that intensify the umami taste up to eight times the intensity of these molecules in isolation (Kurihara, 2015; Schmidt et al., 2020). These findings suggest that we are evolutionary drawn to a high dietary diversity.
Generally speaking, the health benefits of umami is strongly dependent on the food we choose.
Miso
Miso known as a traditional Japanese condiment, is a thick paste produced from fermented soybeans containing salt, koji (fungus species Aspergillus oryzae) and different types of cereal grains. During the fermentation process, enzymes from the fungus, lactic acid bacteria, and yeast break down the organic compounds in soybeans and the cereal grains resulting in a thick soybean paste. Miso is used in both traditional and modern Japanese cuisine and is gaining popularity across the world, not at last due to its exquisite flavour and high protein, vitamin, and mineral contents. Generally, a well-fermented miso paste contains up to 14% protein and is high in free amino acid contents, particularly glutamate which generates the umami taste (Mouritsen & Styrbæk, 2014). Miso holds numerous vitamins in addition to minerals like sodium, calcium, potassium, manganese, copper, zinc and other minerals in smaller amounts. A number of these nutrients carry the necessary structures used for maintenance of the bones as well as the nervous system. Further, miso can potentially increase the digestion by enhancing the probiotic activity and assists the body in maintaining a healthy microbiota (Mouritsen & Styrbæk, 2014).
Shiitake mushrooms
Shiitake mushrooms are rich in key vitamins and minerals while low in calories, fat and protein. Originated from Asia, they now count to one of the most popular mushrooms across the culinary world. The long list of compounds in Shiitake have a track record of potential health benefits such as the potential to prevent cardiovascular diseases (Guillamón et al., 2010), to lower cholesterol levels as well to serve as anticancer treatment (Finimundy et al., 2014).
Irish seaweed
The basis for today’s research on umami started with its discovery in Kombu, an edible seaweed capturing the mouth-watering umami flavour. Kelp is more than just a nutrient-dense, low-fat, low-calorie food. Studies have suggested that kelp may have a substantial effect on weight reduction and obesity due to the presence of alginate, a natural fibre, which can prevent the absorption of fat molecules in the gut (Jensen et al., 2012). Furthermore, Kombu contains a high number of key vitamins and minerals and are an ideal source for natural iodine, a key component needed in the production of thyroid hormones(Choudhry & Nasrullah, 2018). The intake of iodine supplements can therefore be avoided by eating seaweed aa an overdose of iodine by supplements can have a significant effect on our thyroid function and hormone balance (NHS, 2020). Furthermore, a number of studies have suggested potential anti-cancer and anti-inflammatory effects in Kombu ((Choudhry & Nasrullah, 2018; Jensen et al., 2012).
Cherry tomatoes
Tomatoes are an excellent source of Umami flavour. The glutamic acid content gives them a sweet-yet-savory flavour. Regular tomatoes have 150-250mg of glutamic acid per 100 g, whereas cherry tomatoes have 170-280 mg per 100 g. Furthermore, tomato glutamic acid levels continue to rise as they ripen. Drying tomatoes can improve their umami flavour by removing moisture and concentrating glutamate. Each 100 g of dried tomatoes contains 650-1140 mg of glutamic aid. Aside from glutamic acid, tomatoes are also a good source of several vitamins and minerals including vitamin C, Vitamin K, potassium, folate and plant-based antioxidants.
Garlic
Garlic is an Allium (onion) plant grown for its distinctive flavour and health benefits. It contains sulphur compounds, which are thought to account for some of the health benefits.
“Let food be thy medicine, and medicine be thy food”
Those are the famous words of Hippocrates, the ancient Greek physician known as the father of Western medicine. He prescribed garlic to treat a number of medical conditions, and modern science has confirmed many of its health benefits. Scientists now believe that sulphur compounds formed when a garlic clove is chopped, crushed, or chewed are responsible for the majority of garlic's health benefits. Garlic's sulphur compounds enter your body through the digestive tract. They then travel all over the body, exerting strong biological effects. Garlic is known to boost the function of the immune system; the active compounds in garlic can reduce blood pressure Garlic is also rich in vitamin C, vitamin B6 and manganese.
Onion
Though all vegetables are beneficial to health, certain varieties provide additional advantages. Onions are members of the Allium genus, which also includes garlic, shallots, leeks, and chives. Onions are high in nutrients and have been linked to a variety of health benefits such as improved heart health, better blood sugar control, and increased bone density. These vegetables contain a variety of vitamins, minerals, and powerful plant compounds that have been shown to benefit health in a variety of ways. In fact, onions' medicinal properties have been known since ancient times, when they were used to treat ailments such as headaches, heart disease, and mouth sores. This vegetable is high in vitamin C, a nutrient that aids in immune health, collagen production, tissue repair, and iron absorption.
Furthermore, onions are high in fibre and serves as good prebiotic, both of which are essential for good gut health. Prebiotics are types of nondigestible fibre that are broken down by beneficial gut bacteria. Gut bacteria consume prebiotics and produce short-chain fatty acids such as acetate, propionate, and butyrate. According to studies, these short-chain fatty acids improve gut health, boost immunity, reduce inflammation, and improve digestion.
References
Ballard, O., & Morrow, A. L. (2013). Human Milk Composition. Nutrients and Bioactive Factors. In Pediatric Clinics of North America (Vol. 60, Issue 1, pp. 49–74). https://doi.org/10.1016/j.pcl.2012.10.002
Becker, W. M., Kleinsmith, L. J., & Hardin, J. The World of the Cell. 2009.
Bellisle, F., Monneuse, M. O., Chabert, M., Larue-Achagiotis, C., Lanteaume, M. T., & Louis-Sylvestre, J. (1991). Monosodium Glutamate as a Palatability Enhancer in the European Diet. Physiology & Behaviour, 49, 869–873.
Choudhry, H., & Nasrullah, M. (2018). Iodine consumption and cognitive performance: Confirmation of adequate consumption. In Food Science and Nutrition (Vol. 6, Issue 6, pp. 1341–1351). Wiley-Blackwell. https://doi.org/10.1002/fsn3.694
Clark, D. P., & Pazdernik, N. (2012). Molecular biology. Elsevier.
Csapó, J., & Salamon, S. (2009). Composition of the mother’s milk I. Protein contents, amino acid composition, biological value. A review. In Alimentaria (Vol. 2, Issue 2).
Durack, E., Alonso-Gomez, M., & Wilkinson, M. (2008). Salt: A Review of its Role in Food Science and Public Health. Current Nutrition & Food Science, 4(4), 290–297. https://doi.org/10.2174/157340108786263702
European Food Safety Authority (2017). EFSA reviews safety of glutamates added to food. Retrieved October 12, 2022, from https://www.efsa.europa.eu/en/press/news/170712#:~:text=In%20the%20EU%20the%20addition,line%20with%20good%20manufacturing%20practices.
Finimundy, T. C., Dillon, A. J. P., Henriques, J. A. P., & Ely, M. R. (2014). A Review on General Nutritional Compounds and Pharmacological Properties of the Mushroom. Food and Nutrition Sciences, 05(12), 1095–1105. https://doi.org/10.4236/fns.2014.512119
Guillamón, E., García-Lafuente, A., Lozano, M., D́arrigo, M., Rostagno, M. A., Villares, A., & Martínez, J. A. (2010). Edible mushrooms: Role in the prevention of cardiovascular diseases. In Fitoterapia (Vol. 81, Issue 7, pp. 715–723). https://doi.org/10.1016/j.fitote.2010.06.005
Hbf87 (2018). Chemical structure of desoxyadenosine monophosphate. Retrieved October 18, 2022, from https://commons.wikimedia.org/wiki/File:DAMP_chemical_structure.svg
He, F. J., Brinsden, H. C., & Macgregor, G. A. (2014). Salt reduction in the United Kingdom: A successful experiment in public health. In Journal of Human Hypertension (Vol. 28, Issue 6, pp. 345–352). Nature Publishing Group. https://doi.org/10.1038/jhh.2013.105
Hodson, N. A., & Linden, R. W. A. (2006). The effect of monosodium glutamate on parotid salivary flow in comparison to the response to representatives of the other four basic tastes. Physiology and Behavior, 89(5), 711–717. https://doi.org/10.1016/j.physbeh.2006.08.011
Jensen, M. G., Kristensen, M., & Astrup, A. (2012). Effect of alginate supplementation on weight loss in obese subjects completing a 12-wk energy-restricted diet: A randomized controlled trial. American Journal of Clinical Nutrition, 96(1), 5–13. https://doi.org/10.3945/ajcn.111.025312
Kurihara, K. (2015). Umami the Fifth Basic Taste: History of Studies on Receptor Mechanisms and Role as a Food Flavor. In BioMed Research International (Vol. 2015). Hindawi Publishing Corporation. https://doi.org/10.1155/2015/189402
Morales, M. F. (2020). Umami neon light sign. Retrieved October 18, 2022, from https://unsplash.com/@007bfernanda?utm_source=unsplash&utm_medium=referral&utm_content=creditCopyText"
Mouritsen, O., & Styrbæk, K. (2014). Umami. In Umami. Columbia University Press.
Nalivayko, A. (n.d.). Amino acid molecules on white background. Retrieved October 18, 2022, from https://www.shutterstock.com/de/image-illustration/amino-acid-molecules-on-white-background-356703527
Ninomiya, K. (2015). Science of umami taste: adaptation to gastronomic culture. Flavour, 4(1). https://doi.org/10.1186/2044-7248-4-13
Ragesoss. (2008). Crystals of the food additive monosodium glutamate (MSG), from a container branded as "Mimi's Products". Retrieved October 18, 2022, from https://commons.wikimedia.org/wiki/File:Monosodium_glutamate_crystals.jpg
Satoh-Kuriwada, S., Shoji, N., Kawai, M., Uneyama, H., Kaneta, N., & Sasano, T. (2009). Hyposalivation Strongly Influences Hypogeusia in the Elderly. In Journal of Health Science (Vol. 55, Issue 5).
Schiffer, M. (2018). Bacteria Samples. Retrieved October 18, 2022, from https://unsplash.com/photos/13UugSL9q7A
Schmidt, C. V., Olsen, K., & Mouritsen, O. G. (2020). Umami synergy as the scientific principle behind taste-pairing champagne and oysters. Scientific Reports, 10(1). https://doi.org/10.1038/s41598-020-77107-w
U.S. Food & Drug Adminstration (2012). Questions and Answers on Monosodium glutamate (MSG). Retrieved October 12, 2022, from https://www.fda.gov/food/food-additives-petitions/questions-and-answers-monosodium-glutamate-msg#
Yamaguchi, S., & Ninomiya, K. (2000). Umami and Food Palatability. https://academic.oup.com/jn/article/130/4/921S/4686627
Yamamoto, S., Tomoe, M., Toyama, K., Kawai, M., & Uneyama, H. (2009). Can dietary supplementation of monosodium glutamate improve the health of the elderly? American Journal of Clinical Nutrition, 90(3). https://doi.org/10.3945/ajcn.2009.27462X